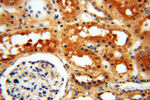
CTTNBP2 Antibody in Immunohistochemistry (Paraffin) (IHC (P))

Search
Proteintech
CTTNBP2 Polyclonal Antibody
{{$productOrderCtrl.translations['antibody.pdp.commerceCard.promotion.promotions']}}
{{$productOrderCtrl.translations['antibody.pdp.commerceCard.promotion.viewpromo']}}
{{$productOrderCtrl.translations['antibody.pdp.commerceCard.promotion.promocode']}}: {{promo.promoCode}} {{promo.promoTitle}} {{promo.promoDescription}}. {{$productOrderCtrl.translations['antibody.pdp.commerceCard.promotion.learnmore']}}
产品信息
17893-1-AP
种属反应
已发表种属
宿主/亚型
分类
类型
抗原
偶联物
形式
浓度
规格
纯化类型
保存液
内含物
保存条件
运输条件
产品详细信息
Immunogen sequence: LSVWRQLNS CLARLGTPEA LLGPKYFLSC PVVPGHAQVT VKWMSKLWNG VIAPRVQEAI LSRASVKRQP GFGQTTAKRH PSQGQQAVVK AALSILLNKA VLHGCPLPRA ELDQHTADFK GGSFPLSIVS SYNTCNKKKG ESGAWRKVNT SPRRKSGRFS LPTWNKPDLS TEGMKNKTIS QLNCNRNASL SKQKSLENDL SLTLNLDQRL SLGSDDEADL VKELQSMCSS KSESDISKIA DSRDDLRMFD SSGNNPVLSA TINNLRMPVS QKEVSPLSSH QTTECSNSKS KTELGVSRVK SFLPVPRSKV TQCSQNTKRS SSSSNTRQIE INNNSKEVNW NLHKNEHLEK PNK (1312-1663 aa encoded by BC106000)
靶标信息
CTTB2 is a protein with six ankyrin repeats and several proline-rich regions. A similar gene in rat interacts with a central regulator of the actin cytoskeleton.
仅用于科研。不用于诊断过程。未经明确授权不得转售。
生物信息学
蛋白别名: Cortactin-binding protein 2; cortactin-binding protein 2 intron retention form; CortBP2; CORTBP2, C7orf8; CTTNBP2 intron retention form; unnamed protein product
基因别名: 3010022N24Rik; 4732477G22Rik; 6430526E05; 9130022E09Rik; AU040881; C7orf8; CORTBP2; CTTNBP2; KIAA1758; mKIAA1758; ORF4
UniProt ID: (Human) Q8WZ74, (Mouse) B9EJA2
Entrez Gene ID: (Human) 83992, (Mouse) 30785